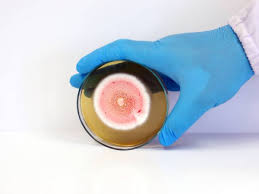

کیت استخراج DNA از قارچ
DNA استخراج شده میتواند در بسیاری از واکنش های پائین دست از جمله PCR، تعیین توالی، تعیین ژنوتایپ، و انواع هیبریدیزاسیون از جمله Southern blotting مورد استفاده قرار گیرد.
درباره ما
ژناسان با هدف خدمت به جامعه علمی کشور در زمینه بیولوژی مولکولی فعالیت دارد. . محصولات این شرکت با کیفیتی بالا از مرغوبترین مواد اولیه و با اجرای موازین و شرایط دقیق آزمایشگاهی و آزمایشات متعدد کنترل کیفی تهیه میشوند. هدف محوری این مجموعه تولید محصولات متنوع و متعدد در زمینههای بیولوژی سلولی و مولکولی با کاربردهای مختلف، با کیفیت بسیار عالی و با قیمتی مناسب برای عرضه به مراکز دانشگاهی و پژوهشی کشور میباشد

محصولات زیست مولکولی
مطابق نیاز شما، با کیفیت و به صرفه!

کیت استخراج DNA از بافت قارچی
اکثر روشهای موجود برای استخراج DNA از انواع نمونه های قارچی با استفاده از پروتوکل های بسیار وقت گیر و هزینه بر انجام می گیرد که این روشها به دلیل استفاده از مواد خطرناکی مانند مرکاپتواتانول، فنول و غیره برای سلامتی انسان بسیار مضر میباشند. همچنین کیت های موجود در بازار که برای استخراج DNA قارچها مورد استفاده قرار میگیرند در بیشتر موارد دارای مراحل بسیار طولانی که گاهی اوقات مستلزم صرف یک روز کاری زمان میباشد، هستند و هزینه زیادی را بر دوش محققان و دانشجویان در مراکز تحقیقاتی تحمیل میکنند که از نظر اقتصادی مقرون به صرفه نمیباشد.
محلولهای موجود در کیت کیت استخراج
محلول S1:
برای افزایش حجم نمونه و تنظیم ترکیب بافری آن استفاده میشود.
محلول S2:
باعث شکست دیواره سلولی شده و در اتصال DNA به ستون کمک میکند.
محلول S3:
برای آزادسازی و بازیابی DNA از ستون استفاده میشود.
ویژگی های عملکردی

بازده عالی
کاربری ساده و سریع

استخراج سریع و کارآمد دی ان ای ژنومی از بافت قارچی

به حداقل رساندن آسیبهای وارده به اسیدهای نوکلئیک در حین عمل استخراج

عدم نیاز به حلالهای آلی مضر مثل فنل و کلروفرم

